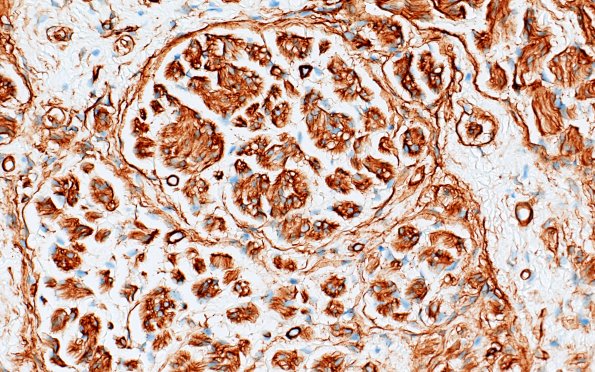
23E2 Neuroma (Case 23) Coll IV area A 40X 2

Table of Contents
Washington University Experience | PERIPHERAL NEUROPATHY | 19 TRAUMATIC INJURIES | 23E2 Neuroma (Case 23) Coll IV area A 40X 2
23E2,3 Higher magnification of image #23E1 showing basement membranes of Schwann cells, perineurial cells and blood vessels. (Coll IV IHC)